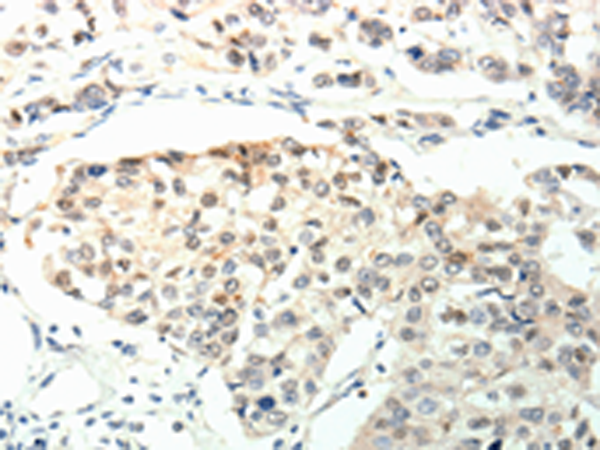

-
分类: 科研抗体货号: P11373别名: MAP1L; MTAP1A应用: IHC反应种属: Human
-
分类: 科研抗体货号: P11372别名: STX1; HPC-1; P35-1; SYN1A应用: WB,IHC反应种属: Human, Mouse, Rat
-
分类: 科研抗体货号: P11392别名: DA1; DA2B; NEM4; TMSB; AMCD1应用: WB,IHC反应种属: Human, Mouse, Rat
-
分类: 科研抗体货号: P11370别名: BRUCE; APOLLON应用: IHC反应种属: Human, Mouse
-
分类: 科研抗体货号: P11413别名: EGFL2; MEGF3; CDHF10; Flamingo1应用: IHC反应种属: Human, Mouse, Rat
-
分类: 科研抗体货号: P11391别名: FR2BP; C12orf5应用: WB,IHC反应种属: Human
-
分类: 科研抗体货号: P11368别名:应用: IHC反应种属: Human
-
分类: 科研抗体货号: P11410别名: SALPR; RLN3R1; RXFPR3; GPCR135应用: IHC反应种属: Human, Mouse
-
分类: 科研抗体货号: P11390别名: TIG1应用: IHC反应种属: Human
-
分类: 科研抗体货号: P11365别名: SS4R; SS4-R; SS-4-R应用: IHC反应种属: Human, Mouse, Rat

鄂公网安备42018502007531号
鄂公网安备42018502007531号

